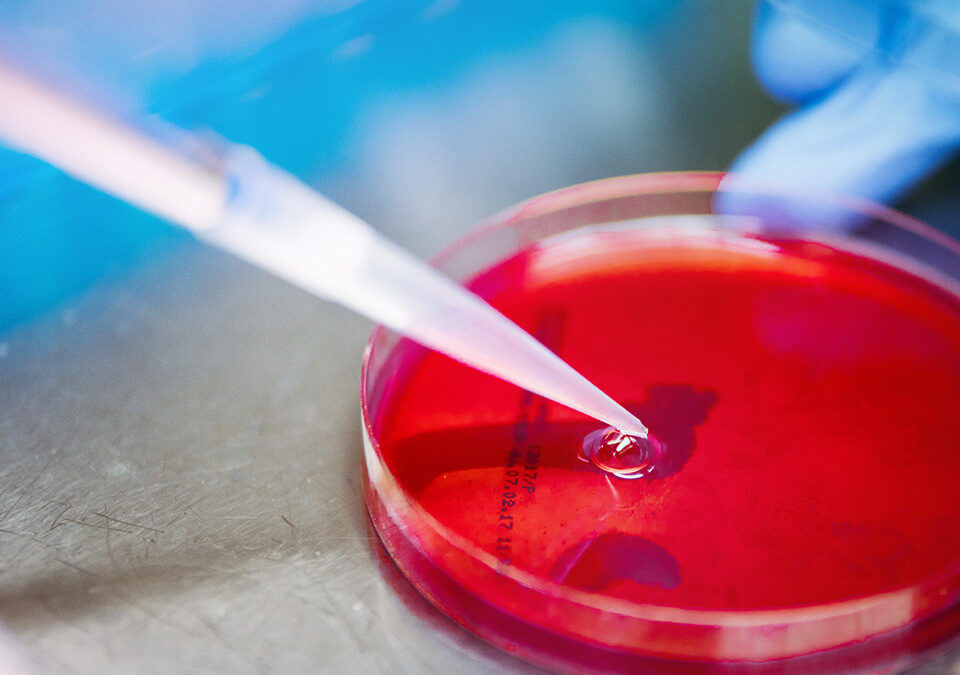

2025-03-10
Klub Pacjenta OnkoCafe to miejsce, gdzie nadzieja splata się z siłą wspólnoty. To tutaj pacjenci onkologiczni odnajdują wsparcie, zrozumienie i przestrzeń do odbudowy – zarówno fizycznej, jak i emocjonalnej.
2025-02-26
Tworzymy wyjątkową przestrzeń pełną ciepła, wzajemnego wsparcia i akceptacji. To miejsce, gdzie każdy może poczuć się bezpiecznie i swobodnie wyrażać swoje emocje – bez lęku przed oceną, z pełnym zrozumieniem i akceptacją ze strony osób, które naprawdę wiedzą, co przeżywasz.
2025-02-25
Każdego dnia w Polsce diagnozę nowotworu otrzymuje około 500 osób. Według najnowszego raportu Krajowego Rejestru Nowotworów* w 2022 roku zdiagnozowano 181,3 tys. nowych przypadków nowotworów złośliwych, a 96 tys. pacjentów zmarło z ich powodu. Te alarmujące dane pokazują, jak ogromnym wyzwaniem jest onkologia i jak istotne jest zapewnienie pacjentom skutecznego leczenia oraz dostępu do nowoczesnych terapii.
2025-02-13
OnkoCafe wraz z 43 innymi organizacjami pacjenckimi podpisała list otwarty do Premiera RP Donalda Tuska, w którym zwraca uwagę na trudną sytuację finansową Narodowego Funduszu Zdrowia i konieczność podjęcia działań stabilizujących system ochrony zdrowia. Pismo,
2025-02-12
Każda przekazana kwota to realne wsparcie dla osób z diagnozą nowotworową oraz ich bliskich. Dzięki Twojej pomocy możemy kontynuować nasze działania, które niosą nadzieję, wsparcie i solidarność.
2025-02-03
Podczas konferencji „Priorytety w Ochronie Zdrowia 2025” temat jakości leczenia nowotworów ginekologicznych oraz hematologicznych w Polsce stanowił jeden z głównych punktów dyskusji.
2025-02-01
Wirus brodawczaka ludzkiego (HPV) to podstępny przeciwnik, który może wpłynąć na zdrowie milionów ludzi na całym świecie. Choć wiele zakażeń ustępuje samoistnie, niektóre typy wirusa mogą prowadzić do poważnych chorób, w tym nowotworów. Czy wiesz, jak skutecznie się przed nim chronić? Oto kluczowe strategie, które pomogą Ci zadbać o zdrowie!
2025-01-27
Tworzymy wyjątkową przestrzeń pełną ciepła, wzajemnego wsparcia i akceptacji. To miejsce, gdzie każdy może poczuć się bezpiecznie i swobodnie wyrażać swoje emocje – bez lęku przed oceną, z pełnym zrozumieniem i akceptacją ze strony osób, które naprawdę wiedzą, co przeżywasz.
2025-01-23
W dniach 20-26 stycznia obchodzony jest Europejski Tydzień Walki z Rakiem Szyjki Macicy.
Jego celem jest zwrócenie uwagi kobiet na to, jak ważne są regularne badania cytologiczne
i ginekologiczne.
2025-01-22
Z wielką dumą i radością gratulujemy sukcesu projektu TakesCare.ai, opracowanego przez Dominika Mazura, który znalazł się w gronie finalistów Konkursu „Zdrowa Przyszłość – Inspiracje 2024”.
2024-07-08
Rusza kolejna edycja kampanii edukacyjnej „ProstaTaHistoria". W tym roku przyjeżdżamy do Waszych miast, aby spotkać się z pacjentami chorującymi na rozrost gruczołu krokowego i raka prostaty, a także z ich bliskimi. Towarzyszyć nam będzie onkolog, który pomoże nam lepiej zrozumieć istotę raka prostaty i opowie o skutecznych metodach leczenia tej choroby.
2024-07-08
Lista TOP 10 HEMATO to zestawienie najważniejszych terapii i leków przeznaczonych do leczenia nowotworów krwi i układu chłonnego, które zdaniem ekspertów powinny zostać objęte refundacją. Niedawno opublikowano najnowszą wersję rankingu wypracowanego na podstawie opinii czołowych polskich hematologów – członków Polskiego Towarzystwa Hematologów i Transfuzjologów. W zestawieniu znajduje się wiele technologii, na udostępnienie których czekają polscy pacjenci.